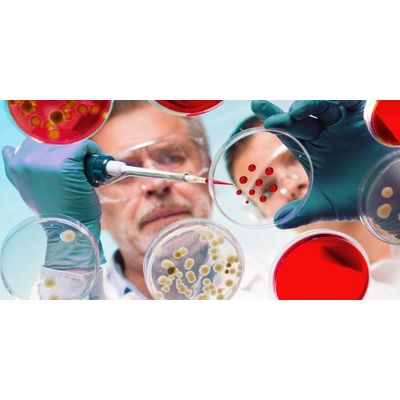

Goodwater Ltd
- Home
- Companies
- Goodwater Ltd
- Services
2 services found
Goodwater Ltd services
Water Hygiene Services
Water is a basic necessity, and an important resource for sustaining life. Failure to look after our water systems can endanger the health of human beings by creating conditions and an environment in which bacteria can appear and grow leading to the spread of diseases.
Laboratory Services
The demands on analytical services are getting higher due to increasingly stringent legislative requirements and other economic and operational factors, requiring a more effective and bespoke service analysis. We use the leading UKAS accredited laboratory to undertake analysis of our samples as we have a duty of care to ensure our clients receive the best available data.